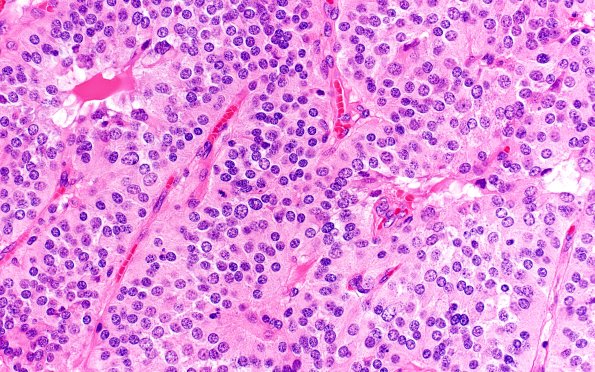
13A3 Paraganglioma (Case 13) H&E 40X 2

Table of Contents
Washington University Experience | NEOPLASMS (NEURONAL) | Paraganglioma - Cauda Equina Neuroendocrine Tumor | 13A3 Paraganglioma (Case 13) H&E 40X 2
H&E-stained sections show a neoplasm arranged in ‘zellballen” or a nested pattern separated by thin fibrovascular septa. The predominant chief cells are polygonal and demonstrate regular round to oval nuclei with finely stippled chromatin and inconspicuous nucleoli. The cytoplasm is eosinophilic and finely granular. The sustentacular cell population is not prominent. Mitoses are fairly abundant, up to 5/10 high power fields.